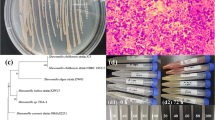

Abstract
Selenate (Se(VI)) and selenite (Se(IV)) are common soluble wastewater pollutants in natural and anthropogenic systems. We evaluated the reduction efficiency and removal of low (0.02 and 2 mg/L) and high (20 and 200 mg/L) Se(IV)(aq) and Se(VI)(aq) concentrations to elemental (Se0) via the use of ascorbic acid (AA), thiourea (TH), and a 50–50% mixture. The reduction efficiency of AA with Se(IV)(aq) to nano- and micro-crystalline Se0 was ≥ 95%, but ≤ 5% of Se(VI)(aq) was reduced to Se(IV)(aq) with no Se0. Thiourea was able to reduce ≤ 75% of Se(IV)(aq) to bulk Se0 at lower concentrations but was more effective (≥ 90%) at higher concentrations. Reduction of Se(VI)(aq)→Se (IV)(aq) with TH was ≤ 75% at trace concentrations which steadily declined as the concentrations increased, and the products formed were elemental sulfur (S0) and SnSe8−n phases. The reduction efficiency of Se(IV)(aq) to bulk Se0 upon the addition of AA+TH was ≤ 81% at low concentrations and ≥ 90% at higher concentrations. An inverse relation to what was observed with Se(IV)(aq) was found upon the addition of AA+TH with Se(VI)(aq). At low Se(VI)(aq) concentrations, AA+TH was able to reduce more effectively (≤ 61%) Se(VI)(aq)→Se(IV)(aq)→Se0, while at higher concentrations, it was ineffective (≤ 11%) and Se0, S0, and SnSe8−n formed. This work helps to guide the removal, reduction effectiveness, and products formed from AA, TH, and a 50–50% mixture on Se(IV)(aq) and Se(VI)(aq) to Se0 under acidic conditions and environmentally relevant concentrations possibly found in acidic natural waters, hydrometallurgical chloride processing operations, and acid mine drainage/acid rock drainage tailings.

ᅟ
Similar content being viewed by others
Explore related subjects
Discover the latest articles, news and stories from top researchers in related subjects.Avoid common mistakes on your manuscript.
Introduction
Selenium is an essential trace element of life, whether it is for animals or plants. Adequate amounts of selenium participate in the antioxidant function of the body regulate the metabolism of thyroid hormones as well as the immune system, and promote the growth of plants (Goldhaber 2003; Lyubenova et al. 2015; Natasha et al. 2018; Ullal et al. 2018). However, excessive amounts of selenium can cause selenium poisoning and ultimately lead to death (Greald et al. 1998; Rayman 2000; Taylor et al. 2009). In nature and in the environment, selenium occurs in natural geologic ore sources such as phosphate rocks, coal, and black shales. Anthropogenic sources of selenium include coal mining, phosphate mining, smelting of sulfide ores, bitumen mining, coal-fired power plants, agriculture, glass manufacturing, and light batteries (Yadak et al. 2005; Wang et al. 2018; USEPA 2002; Qin et al. 2017a; Favorito et al. 2017; Muscatello et al. 2008; Chappell et al. 2014; Fernádez-Martínez and Charlet 2009; Hamilton 2004; Tuzen and Sari 2010; Santos et al. 2015; Wu 2004; Chapman et al. 2010). In natural and mining waste water, typical emission concentrations of selenium can range from 3 μg/L to 200 mg/L (Wasewar et al. 2009; Lemly 2004; Khamkhash et al. 2017; USEPA 2002; Twidwell et al. 2000; Kapoor et al. 1995; Sandy and DiSante 2010; Geoffroy et al. 2008; Geoffroy 2011; Benguerel et al. 2010; Monteith et al. 2000; Santos et al. 2015). In drinking water, the WHO and EPA have a set a guideline of selenium content at 40 μg/L (WHO 2011) and 50 μg/L (USEPA 2009), while the European Union’s limit is much lower at 10 μg/L (European Commission 1998). The speciation of selenium in water systems is ruled by redox conditions, pH, availability of sorbing surfaces, and biological processes (Dinh et al. 2017; Santos et al. 2015; Estevez et al. 2014). In wastewater treatment, selenite (Se(IV)) and selenate (Se(VI)) are the most common soluble wastewater pollutants, while in natural water systems, selenate is dominant (McCloskey et al. 2008).
It is well known that selenite is easier to reduce than selenate via abiotic or biotic means due to the fact the latter has a lower reduction potential (Koyama et al. 2000; McCloskey et al. 2008). The use of many reducing agents such as such as zero-valent iron (ZVI) (Yoon et al. 2016; Qin et al. 2017b; Koyama et al. 2000), green rust (Pefait et al. 2000), FeS2 (Bruggeman et al. 2005), Fe(OH)2 (Sandy and DiSante 2010), Fe(II)(aq) (Sandy and DiSante 2010), humic acid (Peng and Xu 1987), bacteria (Staicu et al. 2015; Kora and Rastogi 2016; Steinberg and Oremland 1990; Oremland et al. 2004), Ni and Cu metal (Sandy and DiSante 2010; Hall et al. 1980), Zn powder (Marchant et al. 1978), CuCl (Misra and Tandon 1967), glucose (Jain et al. 2016; De Coninck 1905), TiCl3 (Tomicek 1927), SnCl2 (Geoffroy 2011), Na2S (Geoffroy et al. 2008; Geoffroy 2011), Na2S2O4 (Geoffroy et al. 2008; Geoffroy 2011), carbohydrazide (Sandy and DiSante 2010), ascorbic acid (Welna et al. 2014, 2017; Matos-Reyes et al. 2010; Pettine 2013; Shaker 1996; Hassan 1991), and thiourea (Welna et al. 2017; Zhang et al. 2011; Alía et al. 1999; Uggerud and Lund 1995; Qiu et al. 2006; Hollander and Yurii 1956) have been documented to treat aqueous selenate and selenite synthetic and industrial wastewater. Unfortunately, some of these reducing agents have setbacks such as high operational or maintenance cost, requirement of higher temperatures, poor efficiencies, and solid-handling problems (e.g., CuCl, TiCl3, thiourea (TH), ascorbic acid (AA), glucose, TiO2, SnCl2, Zn or Cu metal, ZVI, green rust, bacteria, SnCl2), while in other cases, high toxicity of the by-products or reductants themselves (e.g., Fe(OH)2, TiO2, carbohydrazide) has limited their applicability (Sandy and DiSante 2010). Furthermore, some of the reducing agents that have been demonstrated to work in laboratory or industrial case studies such as bacteria (pH 6.5–9), Fe(OH)2 (pH 8–9), TiO2 (pH 3.5), carbohydrazide (pH 2–4), ZVI (pH 4–9), Na2S (pH 2–7), Na2S2O4 (pH 2–3), and ascorbic acid (pH 2–3.5) have optimal reduction pH ranges above 2, thus limiting their use in highly acidic waste streams (Sandy and DiSante 2010; Geoffroy et al. 2008).
The work of Shaker (1996) on the use of ascorbic acid to reduce selenite to elemental selenium used concentrations that were too high to be applicable to wastewater treatment, and furthermore, the pH used was in the range of 2–3. Similarly, other published works (Oremland et al. 2004; Pettine 2013) on the use of ascorbic acid to reduce selenite to elemental selenium have employed selenite concentrations that were too high (e.g., 167 mM) or too low (e.g., 1 μM) to be applicable to wastewater pollution. Currently, there exists no explicit published literature on the effect of ascorbic acid to reduce selenate to selenite to elemental selenium at ambient temperatures. In the case of thiourea, limited work exists in the literature (Qiu et al. 2006; Hollander and Yurii 1956) on its use as a reductants for aqueous selenate or selenite reduction to elemental selenium but often heating above ambient temperatures is required and no insights into the formed phases has ever been given. To the best of the authors’ knowledge, there have been no systematic studies on the reduction efficiency of aqueous selenate and selenite in chloride media to elemental selenium (fairly insoluble and environmentally stable) nor detailed characterization of the products formed using ascorbic acid and thiourea under ambient highly acidic conditions (pH < 1) and relevant wastewater concentrations.
Therefore, in our work, we systematically investigated the reduction efficiency and kinetics of different percentages of ascorbic acid, thiourea, as well as a 50–50% combination of both with low (0.02 and 2 mg/L) to high (20 and 200 mg/L) concentrations of aqueous selenite and selenate under highly acidic chloride media at different reactions times. We further characterize solids generated from high selenite and selenate aqueous concentrations via the use of powder X-ray diffraction, ATR-FTIR, and Micro-Raman to verify if the reduction reactions with ascorbic acid, thiourea, and both had gone to completion (i.e., formed elemental selenium) or if some other undesired compounds were produced (e.g., organo-selenite or selenate, elemental sulfur (S0), and SnSe8−n).
Materials and methods
Chemicals
Stock solutions of 1 g/L Se(IV) and 1 g/L Se(VI) were prepared by dissolving sodium selenite (Na2SeO3) and sodium selenate (Na2SeO4) (98% purity, Shandong West Asia Chemical Industry Co., Ltd.) in distilled water. Thiourea, ascorbic acid (Tianjin Damao Chemical Reagent), and hydrochloric acid (Tianjin Fengchuan Chemical Reagent Technology Co., Ltd.) used in this work were of analytical grade. All glassware was soaked in 5% HNO3 for at least one night before use and then washed with distilled water three times.
Analytical methods
Reactions of different reducing agents on aqueous Se(IV) and Se(VI)
Batch experiments were used to study the reduction efficiency of 0.02 mg/L, 2 mg/L, 20 mg/L, and 200 mg/L Se(IV)(aq), or Se(VI) (aq) with 0.5%, 1%, 2%, and 5% of ascorbic acid, thiourea, as well as a 50–50% mixture of both reducing agents at 2, 6, 10, and 24 h. Our intent in combining both ascorbic acid and thiourea in a 50–50% mixture was to increase the reduction efficiency percentage; removal to the maximum should both behave symbiotically. In our work, a strong acidic environment was employed by using 1.2 M hydrochloric acid solution at room temperature. The reason for using a chloride media environment was that it is often found in coal-fired power plant flue gas desulphurization influent and wastewater, secondary hydrocyclone overflow wastewater from bituminous coal, iron, and steel wastewater, and other selenium containing wastewater environments (Sandy and DiSante 2010; USEPA 2002). These selenium concentrations were chosen because they cover a wide range of waste water concentrations (Khamkhash et al. 2017; USEPA 2002; Twidwell et al. 2000; Sandy and DiSante 2010; Geoffroy 2011; Santos et al. 2015). We chose these percentages of reducing agents because we wanted to use as little as possible to keep their use economical in comparison to others (e.g., SnCl2·2H2O, ZVI, CuCl, NH2NH2 Na2S2O4). Sampling and analysis of the liquid samples during were taken after 2, 6, 10, and 24 h. Finally, in order to verify the nature of the reduced solids produced, only the reduction reaction using 5% reducing agents and 200 mg/L selenite or selenate for 24 h was used as other conditions produced insufficient amount of solids (< 1 mg) for characterization. The reduction solids were obtained by centrifugation, dried naturally in air, and then grinded for characterization.
Liquid analysis methods and characterization of solids
Liquid analysis was conducted on a HG-AFS model SK-2003A two-channel, non-dispersive atomic fluorescence spectrometer (Beijing, Jinsuokun Technology Developing Co., LTD) equipped with a Se hollow cathode lamp (Beijing Shuguangming Electronic Lighting Instrument Co., LTD). The operating parameters used was a high-voltage PMT operating at 260 V, a lamp current of 60 mA, and an Ar carrier and shield flow rate of 600 mL/min and 800 mL/min, respectively. The atomizer temperature used was 400 °C with an atomizer height of 8 mm. The concentrations of KBH4 and KOH used were 1.5% (w/v) and 0.5% (w/v), and our carrier liquid was 1.2 M HCl. The instrumental and our method of detection limit were 0.01 μg/L and < 0.1 ng/g (Welna et al. 2017). In our case, the amount of aqueous Se(VI) in solution was determined by reducing it to Se(IV)(aq) in a water bath and heating it with 6 M HCl at 95 °C for 30 min. The fluorescence intensity was < 300 counts in comparison to the blank solution when the Se(IV)(aq) was zero (Tables S1–S3 and Figs. S1–S3). All solution data presented (Figs. 1, 2, and 3 and Tables S1–S3) are averages of ≥ 2 reproducible tests with a standard deviation ≤ 10%.
The powder XRD analysis was performed with a Bruker D8 advanced diffractometer, a copper target (Cu-Kαλ = 1.5406 Å), a monochromator composed of a graphite crystal, and a scintillator detector. The diffractometer used 40 kV and 40 mA. The scans were recorded between 5 and 90° 2θ with a 0.02° step size and an acquisition time of 0.2 s/step.
ATR-FTIR measurements were collected with a Nicolet 6700 Fourier Transform Infrared Spectrometer (FTIR Spectrometer) from Thermo Fisher using a MIRacle single bounce diamond ATR cell from PIKE Technologies. IR spectra was collected over the 4000–400 cm−1 range via the co-addition of 64 scans and with a resolution of 4 cm−1.
Raman Microscopy was conducted on a Thermo Fisher DXR model using the 50× short distance objective and a polarized argon laser operating at 780 nm and 10% of the laser power at the microscope exit. An average of 10 scans was obtained from 3300 to 60 cm−1 to improve the resolution and the statistics of the collection.
Transmission electron microscopy (TEM) imaging and energy dispersive X-ray analysis (EDX) were conducted on selected particles using a Philips CM-200 microscope operating at 200 kV. The samples were prepared by dropping dilute solutions of the particles in ethanol onto 300-mesh carbon-coated copper grids and evaporating the solvent to dryness before inserting them into the sample holder and vacuum chamber.
Results and discussion
In our work, HG-AFS was employed to detect the different amounts of Se(IV)(aq) and Se(VI)(aq) as a function of different concentrations of the reducing agents and time (Figs. S1–S3 and Tables S1–S3). Se(IV)(aq) was able to be detected without the addition of any reducing agents at all times, and the measured concentrations were close to the theoretical values. However, in the case of Se(VI) (aq), without the addition of reducing agents, the fluorescence intensity and measured concentrations were close to the blank as expected.
The influence of ascorbic acid on the reduction of Se(IV) and Se(VI)
In the case of aqueous Se(IV) at a trace level of 0.02 mg/L (Fig. 1), it can be observed that a rapid decline in fluorescence intensity near that of the blank solution (Table S1 and Fig. S1) was observed at all reaction times investigated and all percentages of ascorbic acid added. The amount of reduction from Se(IV)(aq) to Se0 was initially observed to be ~ 98% after 2 h of reaction time which then decreased to ~ 96% as time increased from 6 to 24 h at all percentages of ascorbic acid added (Fig. 1 and Table S1). At 2 mg/L Se(IV)(aq) (Fig. 1 and Table S1), the decline in fluorescence intensity was gradual with an increase in reaction time from 2 to 24 h (Fig. S1) and the reduction efficiency observed followed (Fig. 1 and Table S1) at all percentages of ascorbic acid added. That is to say, lower reaction times (2, 6 h) gave reduction efficiencies of ~ 98% while those at longer times (10, 24 h) increased to ~ 99% for all percentages of ascorbic acid added. Increasing the Se(IV)(aq) concentration to 20 mg/L (Fig. 1 and Table S1) showed an even slower gradual decrease in fluorescence intensity (Fig. S1) with an increasing reaction time at all percentages of ascorbic acid added, but in this case, the reduction efficiency (Fig. 1 and Table S1) did not follow it in a similar manner as that observed for the 2 mg/L tests. In this case, after 2 h of reaction time, we observed a reduction efficiency of ~ 97% which only slightly increased to ~ 98% after 6 h and then on forward for all percentages of ascorbic acid added. Finally, at the highest concentration used of 200 mg/L Se(IV)(aq), the fluorescence intensity showed a gradual decrease with reaction time (Fig. S1) for all percentages of ascorbic acid added which was similar to that observed at 2 mg/L. The reduction efficiency (Fig. 1 and Table S1) in this case did not follow the fluorescence intensity behavior. In general, we observed that after 2–6 h, ~ 99% of the Se(IV)(aq) had been reduced which then slightly decreased to ~ 98% after 10 h and finally increased to 100% after 24 h for all percentages of ascorbic acid added. In this case (similar to that at 2, 20 mg/L), the full reduction took a bit more time in comparison to that at 0.02 mg/L due to the fact that, at higher concentrations, more Se(IV)(aq) ions were found in solution which needed more time to be effectively reduced from Se(IV)(aq) to Se0. Furthermore, at these high Se(IV)(aq) concentrations, a clear solution and large amounts of brick red precipitates (Levine 1934) (Fig. S4) were observed at all reaction times and percentages of ascorbic acid added; the nature of which will be discussed in “Solid analysis of reduction precipitates from 200 mg/L aqueous se(IV) and se(VI), 24 h, and 5% reducing agents.”
For aqueous Se(VI), the fluorescence intensities (Fig. S1 and Table S1) for all tested aqueous Se(VI) concentrations at all times with all percentages of added ascorbic acid were close to that of the blank solution except for the 200 mg/L tests. Consequently, it indicates that only a small portion of the aqueous Se(VI) had been reduced to Se(IV)(aq). At trace levels of aqueous Se(VI) (Fig. 1 and Table S1), namely, 0.02 mg/L, ≤ 0.5% was reduced to Se(IV)(aq) after 2 h of reaction time and only a maximum of 2.7–4.6% was converted to Se(IV)(aq) after 6–24 h at all percentages of ascorbic acid added. When 2 mg/L of Se(VI)(aq) was added to the solution (Fig. 1 and Table S1), ≤ 0.5% of it was converted to Se(IV)(aq) at all percentages of ascorbic acid added and all reaction times. In this case, a small correlation between percentage of ascorbic acid added and the amount of reduced Se(IV)(aq) was observed at 2–6 h. We observed that as we increased the percentage of ascorbic acid added to the Se(VI)(aq), the lower the reduction efficiency in solution and the less the amount of Se(IV)(aq) that was detected. At 20 mg/L of aqueous Se(VI), the reduction efficiency was observed to be ≤ 0.2% at all percentages of ascorbic acid added and all reaction times. This was similar to what was observed at 2 mg/L thus indicating that the reduction of Se(VI)(aq)→Se(IV)(aq) was very small in comparison to what was observed at 0.02 mg/L. However, in this case, the reduction efficiencies remained fairly constant as the percentage of ascorbic acid increased for all reaction times tested. At the highest concentrations used (200 mg/L of Se(VI)(aq)), the reduction efficiency to Se(IV)(aq) decreased from 2% after 2 h to 0% after 24 h at all percentages of ascorbic acid added. Accordingly, it indicates that longer reaction times were not favorable for the reduction of Se(VI)(aq)→Se(IV)(aq). In this case, the reacting solutions remained largely clear/transparent for all percentages of ascorbic acid added at all reaction times (Fig. S4) and no solids were precipitated. This is unlike that of the Se(IV)(aq) case in which a clear solution and red precipitates were observed.
The influence of thiourea on the reduction of aqueous Se(IV) and Se(VI)
The fluorescence intensity of aqueous Se(IV) at trace levels (0.02 mg/L) was observed to decrease as the amount of thiourea added and reaction time was increased (Fig. S2 and Table S2). This is in contrast to what was observed at the same Se(IV)(aq) concentration with ascorbic acid (Fig. S1 and Table S1) and is indicative that a greater portion of the aqueous Se(IV) remained in solution and was not reduced to Se0 with thiourea. In general, it can be observed (Fig. 2 and Table S2) that as the amount of thiourea added and time increased, the percentage of reduction efficiency from aqueous Se(IV) to Se0 increased ranging from 46 to 77% after 2–24 h and 0.5–5% thiourea added. For the 2 mg/L case, the fluorescence intensity increased to a lower degree (Fig. S2 and Table S2) (in comparison to that of trace level Se(IV)(aq)) as the amount of thiourea added increased, but again, it was in contrast to what was observed at the same concentrations with ascorbic acid. Thus again, it indicates that a larger portion of the aqueous Se(IV) remained in solution and was not reduced to Se0 relative to the ascorbic acid experiments. Herein, the majority of the percent reduced Se(IV)(aq) efficiency occurred between 0.5–1.0% added thiourea ranging from 66 to 75% at 2–24 h after which it decreased to ~ 62% as the amount of thiourea added increased for all reaction times. At 20 mg/L aqueous Se(IV), the fluorescence intensity (Fig. S2 and Table S2) resembled a parabolic type of behavior that decreased lower in intensity with longer reaction times. In this case, no evident correlation with the amount of reduction percentage efficiency was observed at all reaction times as the amount of percent thiourea added increased as was observed at 0.02 and 2 mg/L. However, as the reaction time increased from 2 to 24 h, the amount of percent reduced aqueous Se(IV) to Se0 increased from ~ 89–93% for all percentages of thiourea added. Finally, at the highest concentration of 200 mg/L aqueous Se(IV) tested, we could observe that the fluorescence intensity (Fig. S2 and Table S2) resembled again a parabolic type of behavior observed at 20 mg/L but was in contrast to what was observed for the ascorbic acid case (Fig. S1). Here, we measured an increase in reduction efficiency (Fig. 2 and Table S2) of Se(IV)(aq)→Se0 from 96 to 98% as the amount of thiourea increased from 0.5–2.0% and 2–24 h. After which, it converged to ~ 97% at 5% thiourea added and all reaction times. It is worth to note to the reader that, at this high concentration of aqueous Se(IV), the reacting solutions turned clear with a red precipitate forming (Fig. S5) whose identity will be discussed in “Solid analysis of reduction precipitates from 200 mg/L aqueous se(IV) and se(VI), 24 h, and 5% reducing agents.”
In the case of aqueous Se(VI), the fluorescence intensity (Fig. S2 and Table S2) for all tested Se(VI) concentrations and percentages of thiourea added were not near the blank solution as observed in the ascorbic acid case. Instead, they increased in intensity as the amount of added thiourea increased. Thus, it indicates that in this case, a larger portion of the Se(VI)(aq) had been reduced to Se(IV)(aq) in comparison to the ascorbic acid experiments. At the lowest concentrations of Se(VI)(aq) tested (0.02 mg/L), the fluorescence intensity (Fig. S2 and Table S2), as well as the reduction efficiency (Fig. 2 and Table S2), increased with the added amount of percent thiourea from 14 to 74% between 2 and 24 h. It is worth to note that in this case, a longer reaction times caused a decrease in reduction efficiency where the maximum reduction efficiency occurred after 2 h. At 2 mg/L Se(VI)(aq), we observed the fluorescence intensity (Fig. S2 and Table S2) as well as the reduction percentage efficiency (Fig. 2 and Table S2) increase with the added amount of percentage thiourea from 11 to 29% between 2 and 24 h. However, in this case, we observed that longer reaction times had a positive effect on the reduction efficiency as the largest reduction occurred after 24 h. Once 20 mg/L of Se(VI)(aq) was tested, again, a similar trend was observed as that which was observed at 0.02 mg/L. The fluorescence intensity (Fig. S2 and Table S2) as well as the reduction efficiency percentage (Fig. 2 and Table S2) increased with percentage thiourea added from 5 to 12% after 2–24 h. Again, here, we observed that longer reaction times larger than 2 h had a negative effect on the reduction efficiency as the maximum efficiency occurred after 2 h of reaction time. Finally, at the largest Se(VI)(aq) tested (i.e., 200 mg/L), we observed a fluorescence intensity and reduction efficiency behavior similar to what was observed at 2 mg/L. Namely, the fluorescence intensity and reduction efficiency increased with the amount of percent thiourea added from 2 to 4% between 2 and 24 h. Again, longer reaction times had a positive effect on the reduction efficiency as the largest efficiencies occurred after 10 h of reaction time. In this case, unlike that of ascorbic acid at the same Se(VI)(aq) concentrations, the solution turned from clear to a yellow-orange like precipitate (Fig. S5) whose identity will be discussed in more detail in “Solid analysis of reduction precipitates from 200 mg/L aqueous se(IV) and se(VI), 24 h, and 5% reducing agents.”
The influence of both ascorbic acid and thiourea on the reduction of aqueous Se(IV) and Se(VI)
Our intent in combining both ascorbic acid and thiourea in a 50–50% mixture was to increase the reduction efficiency percentage to the maximum amount possible should both reducing agents behave in concerto. However, our results showed some peculiar solution behavior as discussed below.
For aqueous Se(IV) at 0.02 mg/L, the fluorescence intensity (Fig. S3 and Table S3) behaved like that of thiourea alone and not ascorbic acid nor a combination of both. The reduction efficiency percentage (Fig. 3 and Table S3) behavior was only slightly similar to thiourea. Regardless, a similar portion of the Se(IV)(aq) remained in solution as was observed in the thiourea case. In general, we observed that as the amount of AA+TH added increased at shorter reaction times (2 and 6 h), the reduction efficiency ranged from 42 to 60%, while at longer reaction times (10 and 24 h), the reduction efficiencies decreased from 72 to 41%. In this case, the combination of AA+TH gave similar reduction efficiency percentages as was observed for the isolated thiourea experiments. At 2 mg/L Se(IV)(aq), the fluorescence intensity (Fig. S3 and Table S3) and the reduction percentage behavior (Fig. 3) resembled the thiourea tests. In this case, we detected that the more AA+TH that was added, the reduction efficiency percentage decreased from ~ 81–66% for all reaction times. In here, it was again observed that longer reaction times generally had a positive effect on the reduction efficiency by increasing it. This latter fact is something that was not so clearly observed at the same Se(IV)(aq) concentrations with the use of thiourea alone. Interestingly, the combination of AA+TH did increase the overall percentage of Se(IV)(aq) reduced in comparison to thiourea alone but was lower than that of ascorbic acid (Figs. 1, 2, and 3 and Tables S1–S3). Using 20 mg/L Se(IV)(aq), we could observe that the fluorescence intensity (Fig. S3) behaved like it was observed for the thiourea case and the reduction efficiency percentage behavior (Fig. 3) was unlike that of the ascorbic acid nor thiourea. In general, we measured that as the amount AA+TH increased from 0.5–5%, the lower the reduction efficiency percentage of Se(IV)(aq) to Se0 ranging from 96 to 90% at all reaction times. Furthermore, here, we observed that the longer the reaction time, the higher the reducing efficiency obtained at all percentages of AA+TH added. The combination of AA+TH showed slightly higher efficiencies than the thiourea case alone but was still lower than ascorbic acid. At the highest concentration of Se(IV)(aq) used (i.e., 200 mg/L), the fluorescence intensity (Fig. S3) behavior was unlike that of thiourea but resembled that of ascorbic acid with the exception that the kinetics were much slower with time. Interestingly, the reduction efficiency behavior (Fig. 3) was only slightly similar to that of thiourea and unlike that of ascorbic acid. This latter fact shows an important behavior that should be considered; although, the fluorescence intensity profile showed one type of behavior, the reduction efficiency does not always follow the same trend. In this case, as the amount of AA+TH added increased at shorter reaction times (2 and 6 h), the higher the reduction efficiency that was measured from Se(IV)(aq)→Se0, while at longer reaction times, the efficiency remained constant. In general, a range between 97 and 100% reduction of Se(IV)(aq) to Se0 was observed for the tested conditions. The combination of AA+TH at such high Se(IV)(aq) concentrations was similar to both ascorbic acid and thiourea tests alone and did not show any significant increase in reduction efficiency. In this case, upon the reduction of 200 mg/L Se(IV)(aq), the solutions were transparent with red precipitates at the bottom (Fig. S6) whose identity will be discussed in “Solid analysis of reduction precipitates from 200 mg/L aqueous se(IV) and se(VI), 24 h, and 5% reducing agents.” It is worth to note that we can hypothesize that the reason why lower reduction efficiencies (≤ 81%) were observed at Se(IV)(aq) concentrations (0.02 and 2 mg/L) with AA+TH may be a result of the fact that, at these concentrations, the reduction efficiency percentage quantity behaved like TH for which the amount of reduction efficiency percentage was always ≤ 81% (Fig. 2). This lower reduction percentage observed for TH maybe a result of the fact that it has been documented that, upon its reaction with Se(IV)(aq), it may form [NH2-C(NH)-S-Se-S-(NH)C-NH2] complexes which may inhibit to some degree its full reduction to Se0. Higher reduction efficiencies (≥ 90%) were observed at higher Se(IV)(aq) concentrations (20 and 200 mg/L) upon the addition of AA+TH likely due to the fact that the system had contributions from both components (i.e., AA and TH) for which their individual reduction efficiencies were always ≥ 90% (Figs. 1 and 2).
In the case of aqueous Se(VI) at trace concentrations (0.02 mg/L), the fluorescence intensity (Fig. S3) and the reduction percentage efficiency (Fig. 3) were like that of thiourea as we observed an increase in reduction efficiency percentage of Se(VI)(aq) to Se(IV)(aq) from 12 to 61% as the amount of AA+TH increased. However, unlike that of thiourea alone (Fig. 2), upon the increase of time, the reduction percent efficiency increased at all percentages of AA+TH added (Fig. 3). Furthermore, the combination of AA+TH resulted in a slight decrease in comparison to thiourea alone but was still much higher in comparison to ascorbic acid (Tables S1–S3 and Figs. S1–S3). A similar trend was observed at 2 mg/L Se(VI)(aq) where the fluorescence intensity, and the reduction efficiency percentage were like that of the isolated thiourea case (Figs. 2 and 3 and Figs. S2–S3). However, in this case, unlike the thiourea tests, we observed the reduction efficiency percentage decrease from Se(VI)(aq) to Se(IV)(aq) with time from 40 to 11% as the amount of AA+TH added increased (Figs. 2 and 3 and Tables S2–S3). Here, an increase in the reduction efficiency percentage of Se(VI)(aq) to Se(IV)(aq) was observed upon the addition AA+TH in comparison to thiourea alone. Interestingly, upon the addition of 20 mg/L Se(VI)(aq), the fluorescence intensity and the reduction efficiency percentage resembled that of thiourea. In general, after the addition of 20 mg/L of Se(VI)(aq), the reduction efficiency percentage decreased from 11 to 4% with longer reaction times at all percentages of AA+TH added. Little to no correlation with an increase in percent of AA+TH added and reduction efficiency was observed for all reaction times tested. In this case, we observed a slight decrease in the reduction efficiency upon the combination of AA+TH in comparison to thiourea alone, but it was still much higher than the ascorbic acid experiments (Figs. 1, 2, and 3 and Tables S1–S3). Finally, at the highest Se(VI)(aq) concentration used (i.e., 200 mg/L), a similar behavior was observed as previously described at 20 mg/L Se(VI)(aq). The fluorescence intensity and reduction efficiency (Fig. 3 and Fig. S3) profiles were similar to that of thiourea with the exception that the highest intensity, as well as the reduction efficiency (2.7%), was observed for the shortest reaction time of 2 h which then decreased with time (1.7%) as the amount of AA+TH increased. This behavior was the inverse of what was observed for thiourea alone, thus indicating that longer reaction times were unfavorable in converting Se(VI)(aq)→Se(IV)(aq) as the amount of AA+TH added increased. The addition of AA+TH resulted in slightly lower reduction percentage efficiencies in comparison to that of thiourea alone but were still higher than those observed for ascorbic acid (Figs. 1, 2, and 3 and Tables S1–S3). It is worth to note that upon the reduction of 200 mg/L Se(VI)(aq), the reacting solutions had a slightly orange tint with reddish-orange solid precipitates forming (Fig. S6); the characteristics of which will be discussed in “Solid analysis of reduction precipitates from 200 mg/L aqueous se(IV) and se(VI), 24 h, and 5% reducing agents.”
Solid analysis of reduction precipitates from 200 mg/L aqueous Se(IV) and Se(VI), 24 h, and 5% reducing agents
In order to confirm the nature of the solids precipitated in our reactions, we decided to analyze them at the structural and molecular level to observe if indeed the majority of the precipitated reduction products formed were that of elemental selenium (Se0) as desired. However, as previously noted, only solids at 200 mg/L Se(VI)(aq)/Se(IV)(aq) with 5% added reducing agent(s) and 24 h of reaction time produced enough mass of the solids to conduct characterization analysis. The only exception has been Se(VI)(aq) with ascorbic acid which produced no solid precipitates due to the low amount of reduction. The XRD, Micro-Raman, and ATR-IR of reference compounds (Se0, S0, ascorbic acid, and thiourea), our reacted samples and their assignments are shown in Figs. 4, 5, and 6 and Figs. S7–S9 and Tables S4–S6.
In the case of Se(IV)(aq) with ascorbic acid, the Raman spectra (Fig. 4) showed characteristics of Se–Se stretches but shifted to higher energy (~ 247 cm−1) and with a broader full width at half max (FWHM) in comparison to the standard elemental Se0. The latter characteristic (broad FWHM) can be reasoned as a result of the fact that the generated Se0 took a nano-crystalline (Hemalatha et al. 2014) or a semi-crystalline type of form. The shift to higher energy may be attributed to some interactions (e.g., strain/distortion) occurring between the Se–Se bonds and/or lattices domains or due to a nano-crystalline nature or due to the fact that it may have formed the less common Se6 structures as observed by Oremland et al. (2004) who observed shifts to higher energies (~ 241 and 244 cm−1) for the main scattering peak. Our Raman observations are in agreement with the work of Ezhuthupurakkal et al. (2017) who also observed a similar Raman band at ~ 250 cm−1 which they attributed to be from a nano-crystalline trigonal Se0 phase. To further verify the nano-crystalline nature of the Se0 nano-particles inferred to be observed from the Raman data, additional TEM analysis was undertaken. From the TEM images (Fig. 5 and Fig. S7), we confirmed that indeed the Se0 particles formed were composed of nano-crystalline agglomerates (50–100 nm) that formed micron size spherical particles (1–2 μm) out of which sharp shaped needles (1.5–1.6 μm) grew. Furthermore, in addition to the well-ordered lattice fringes from the (010) at 3.8 Å and (012) at 2.1 Å, we observed a small domain of lattice fringes with spacing’s of 4.1 Å (unindexed based on Se0 crystallographic data) as well as distorted lattice fringe domains which likely contributed the observed shifts to higher energies observed in the Raman spectra (Fig. 4). From the XRD data (Fig. 4), no distinct crystalline peaks were observed from Se0 but rather two broad peaks at 29.5° and 51.8° and a crystalline peak at 34.6° were observed. The XRD results are in agreement with the Raman and TEM data indicating that the produced Se0 was composed of a nano-crystalline nature as observed in the work of Ezhuthupurakkal et al. (2017) but also some micro-crystalline component. The ATR-IR spectra (Fig. 6) indicated some ascorbic acid had re-precipitated but based on the positions as well as the symmetry of the major bands/functional groups (Table S6) of the pure ascorbic acid, and the re-precipitated ascorbic acid, we can infer that no chemical bonding interactions occurred between the nano- nor micro-crystalline Se0 and the re-precipitated ascorbic acid. Therefore, it indicates that the Se0 precipitated as an independent phase.
As we hypothesized from the red color of the solid, in the case of Se(IV)(aq) with thiourea alone, the Raman spectra (Fig. 4) showed only characteristic Se–Se stretches at 233 cm−1 typical of Se0 with no characteristic bands from SnSe8−n compounds nor that of elemental sulfur (S0) (Alía et al. 1999; Ward 1968; Laitnen and Steudel 1980). Similarly, the XRD (Fig. 4) showed all major diffraction planes belonged to that of pure hexagonal Se0 with no major traces of impurities. Interestingly, the ATR-IR spectra (Fig. 6) again showed that some residual amount of thiourea had re-precipitated from solution but based on the major bands/functional group positions, the interaction between the Se0 and thiourea were purely physical (i.e., they both co-precipitated as separate phases). This latter fact has interesting implications in the fact that the re-precipitated thiourea could be separated, recycled, and reused for further Se(IV)(aq) reduction. However, in our work, the latter implication was not tested as it was out of the scope of the current work.
For tests conducted with AA+TH and Se(IV)(aq), the Raman spectra (Fig. 4) showed a clear Se–Se vibrational structure at 232 cm−1 typical of Se0 with no indications of SnSe8−n and elemental sulfur (Alía et al. 1999; Ward 1968; Laitnen and Steudel 1980). In agreement, the XRD data (Fig. 4) showed only the presence of pure hexagonal Se0 with no major traces of impurities. The ATR-IR data showed that a mixture of AA+TH re-precipitated (Fig. 6), but again, the formation of the latter is independent of the formation of Se0.
The reduction of Se(VI)(aq) with ascorbic acid showed that no solids formed due to the low reduction efficiency percentage observed from Se(VI)(aq) to Se(IV)(aq). We reasoned this to be a result of the fact that perhaps, in this case, some insoluble Se(VI)-AA complexes formed which were not favorable to precipitate under the reacting conditions used or that the reduction reaction is extremely slow under acidic conditions.
In the case of Se(VI)(aq) with thiourea, the Raman spectra (Fig. 4, Fig. S8) showed no distinct Se0 stretches between 233 and 245 cm−1 but rather the appearance of S–S stretches at 147, 212 and 469 cm−1 from elemental sulfur (Ward 1968) as well as that of Se–S vibrations from SnSe8−n compounds between 260 and 433 cm−1 (Alía et al. 1999; Ward 1968; Laitnen and Steudel 1980). Our Raman analysis is in agreement with the fact that we observed yellow-orange precipitates upon the addition of thiourea. The XRD analysis (Fig. 4, Fig. S8) again showed no presence of Se0 and was dominated by S0, in agreement with our Raman analysis. In this case, no thiourea was re-precipitated out of solution as observed from the ATR-IR data (Fig. 6).
Finally, reduction of Se(VI)(aq) with AA+TH gave Raman spectra (Fig. 4, Fig. S9) that showed the presence of Se–Se stretches (Se0) at 232 cm−1 as well as that of S–S stretches (S0) at 462 cm−1 and Se–S vibrations from SnSe8−n type of compounds between 249 and 350 cm−1 (Alía et al. 1999; Ward 1968; Laitnen and Steudel 1980). The vibrational analysis was again in agreement with the fact that a reddish-orange type of solids formed upon the addition of AA+TH. The XRD data (Fig. 4, Fig. S9) showed only the presence of Se0 with no clear indication of a major percentage of S0 as was observed in the thiourea alone experiment. Hence, it indicates that the amount of S0 was not significant. The ATR-IR data (Fig. 6) showed that only a small amount of thiourea had re-precipitated from solution with no clear signs of ascorbic acid.
Environmental implications
In natural water such as aquifers, crater lakes and hot springs in active geothermal areas sources from magmatic gases can contribute HCl, HF, and H2SO4 which will cause extreme acidic conditions (pH ≤ 1) (Nordstrom et al. 2000) where natural contaminants in the form of aqueous selenium in various oxidation states maybe present and may have detrimental effects to the surrounding environment and natural wild life.
Similarly, aqueous selenium in various oxidation states is a common unwanted impurity that must be removed in numerous mining industries (e.g., Zn, Ni, Pb, Cu refineries, U, Au, and Ag acid leaching of ores as well as coal mining operations) for which a highly acidic chloride environment (pH ≤ 1) may be present as a result of the hydrometallurgical chloride (Winand 1991; Adams 2016) technology used (e.g., CESL process (Mayhew et al. 2013), Hydrocopper™ (Hyvarinen et al. 2004), Kell Process (Lidell and Adams 2012), Intec/N-chlo process (Severs 1999; Moyes 1999), Neomet gold process (Harris and White 2011a, b), ZINCEX process (Winand 1991), ELKEN-Falconbridge process (Winand 1991), ORTECH Inc. processes (Winand 1991)), or from chloride-containing mineral sources present in the original ore or concentrate.
Furthermore, acid mine drainage (AMD) and acid rock drainage (ARD) from mine waste rock dump tailings or coal spoils (Egiebor and Oni 2007; Gray 1996; Sandy and DiSante 2010; Banks and Banks 2001; Johnson and Hallberg 2005) may contain highly acidic (pH ≤ 1) chloride environments where unwanted aqueous selenium in various oxidation states leaching from the waste tailings may occur and cause harm to the surrounding natural water and its organisms present.
As can be observed from the extensive literature reviews on selenium treatment technologies (Sandy and DiSante 2010; Khamkhash et al. 2017; Santos et al. 2015) for natural and anthropogenic contaminated water systems as well as our own comparison (Table 1), there exists a lack of application method(s) to treat aqueous selenium in various oxidation states in-situ without neutralization for highly acidic (pH ≤ 1) water systems that may be dominated in chloride environments. Therefore, our research presented in this work provides an alternative practical inexpensive method to remediated Se(IV)(aq) and Se(IV)(aq) in situ without the need for neutralization at ambient conditions under highly acidic (pH ≤ 1) chloride environments which may be observed in natural, hydrometallurgical processing operations and AMD/ARD tailings.
A limitation of this study is the fact that the presence of H2SO4 which is quite common in natural, hydrometallurgical processing as well as AMD/ARD environments was not included as a result of the fact it was out of the scope of this study. Therefore, future studies to investigate the effectiveness of AA, TH, and AA+TH in reducing Se(IV)(aq) and Se(IV)(aq) to Se0 in the presence of both HCl and H2SO4 will be undertaken as limited (TH with Se(IV)(aq) (Hollander and Yurii 1956)) or no studies exist on this matter.
Conclusion
In this work, we investigated the reduction efficiency of ascorbic acid, thiourea, and a 50–50% mixture of low to high concentrations of Se(VI)(aq) and Se(IV)(aq) to form Se0 as a function of time, percent reductant added, and ambient highly acidic chloride media. Based on our experimental data and results, the following conclusions can be made:
-
Ascorbic acid was able to reduce ≥ 95% of Se(IV)(aq) to nano- and micro-crystalline Se0 under all reaction conditions tested and thus maybe used to treat highly acidic chloride-containing waste water under ambient conditions in a wide range of Se(IV)(aq) concentrations quickly and effectively. In contrast, ≤ 5% of Se(VI)(aq) was reduced to Se(IV)(aq) with no evidence of Se0 solids which has been produced under all reaction conditions tested.
-
The effectiveness of thiourea to reduce Se(IV)(aq) to bulk Se0 was ≤ 75% at low Se(IV)(aq) concentrations (0.02 and 2 mg/L) and ≥ 90% at higher concentrations (20 and 200 mg/L) at all percentages of thiourea added and all reaction times tested. Thus, its use is only recommended at higher Se(IV)(aq) concentrations. Thiourea reduced ≤ 75% of Se(VI)(aq)→Se(IV)(aq) at 0.02 mg/L concentrations which steadily dropped to ≤ 29%, 12%, 3% at 2 mg/L, 20 mg/L, and 200 mg/L at all reaction times and percentages of thiourea added. In this case, mixtures of S0 and SnSe8−n products were formed with no evidence of Se0.
-
The combination of AA+TH was able to reduce ≤ 80% of Se(IV)(aq) to bulk Se0 at low concentrations (0.02 and 2 mg/L) and ≥ 92% at higher concentrations (20 and 200 mg/L) for all reaction times tested and all percentages of AA+TH added. Thus, it makes it suitable for treating Se(IV)(aq) in highly acidic chloride waste streams under ambient temperatures. In contrast, AA+TH reduced ≤ 61% of Se(VI)(aq) to Se(IV)(aq) at low concentrations (0.02 and 2.0 mg/L) and ≤ 10% at higher concentrations (20 and 200 mg/L) under all reaction conditions tested. Furthermore, the combinations of AA+TH-produced solids were mixtures of Se0, SnSe8−n, and S0.
References
Adams MD (2016) Gold ore processing: project development and operations, Second edn. Elsevier, Amsterdam ISBN: 978-0-444-63658-4
Alía JM, Edwards HGM, Fernández A, García-Navarro FJ, Prieto M (1999) FT-Raman spectra of cis–bis (thiourea) selenium(II) chloride and bromide. J Mol Struct 510:107–112
Banks SB, Banks D (2001) Abandoned mines drainage: impact assessment and mitigation of discharges from coal mines in the UK. Eng Geol 60(1–4):31–37
Benguerel E, Seyer N, Geoffroy N, Le Regent A (2010) Upgrading the selenium removal process for CEZinc’s acid plant effluents. In: Centomo L (ed) Zinc and Lead Metallurgy. Canadian Institute of Mining, Metallurgy, and Petroleum, Vancouver, pp 131–139
Bruggeman C, Maes A, Vancluysen J, Vandemussele P (2005) Selenite reduction of boom clay: effect of FeS2, clay minerals and dissolved organic matter. Environ Pollut 137:209–221
Chapman PM, Adams WJ, Brooks M, Delos CG, Luoma SN, Maher WA, Ohlendorf HM, Presser TS, Shaw DP (2010) Ecological assessment of selenium in the aquatic environment. A SETAC Pellston Workshop. SETAC, Pensacola
Chappell MA, Seiter JM, Bednar AJ, Price CL, Averett D, Lafferty B, Tappero R, Stanley JS, Kennedy AJ, Steevens JA, Zhou P, Morikawa E, Merchan G, Roy A (2014) Stability of solid-phase selenium species in fly ash after prolonged submersion in natural river system. Chemosphere 95:174–181
CH2M Hill (2013) NAMC White Paper Report Addendum Selenium Treatment; Technical addendum; CH2M Hill:Englewood, CO, USA, 29 March pp. 1–68
De Coninck WO (1905) Action of dextrose on selenious acid. CR Hbd Acad Sci 141:1234–1235
Dinh QT, Li Z, Tran TAT, Wang D, Liang D (2017) Role of organic acids on the bioavailability of selenium in soil: a review. Chemosphere 184:618–635
Egiebor NO, Oni B (2007) Acid rock drainage formation and treatment: a review. Asia Pac J Chem Eng 2:47–62
Estevez H, Garcia-Lidon JC, Luque-Garcia JL, Camara C (2014) Effects of chitosan-modified selenium nanoparticles on cell proliferation, apoptosis and cell cycle pattern in HepG2 cells: comparison with other selenospecies. Colloids Surf B: Biointerfaces 122:184–193
European Commission (1998) Council directive 98/83/EC of 3 November 1998 on the quality of water intended for human consumption. Off J Eur Communities pp 32–54. https://eur-lex.europa.eu/legal-content/EN/TXT/?uri=CELEX%3A31998L0083
Ezhuthupurakkal PB, Polaki LR, Arumugam S, Ariraman S, Venugopal S, Chinnasamy T (2017) Selenium nanoparticles synthesized in aqueous extract of Allium sativum perturbs the structural integrity of calf thymus DNA through intercalation and groove binding. Mater Sci Eng C 74:597–608
Favorito JE, Luxton TP, Eick MJ, Grossl PR (2017) Selenite speciation in phosphate mine soils and evaluation of a sequential extraction procedure using XAFS. Environ Pollut 229:911–921
Fernádez-Martínez A, Charlet L (2009) Selenium environmental cycling and bioavailability: a structural chemist point of view. Rev Environ Sci Biotechnol 8:81–110
Geoffroy N (2011) Selenium removal from aqueous solutions. Ph.D. Thesis. McGill University
Geoffroy N, Benguerel E, Demopoulos GP (2008) Precipitation from weak acidic solutions using sodium dithionite and sodium sulphide. In: Centomo L (ed) Zinc and Lead Metallurgy. Canadian Institute of Mining, Metallurgy, and Petroleum, Winnipeg, pp 295–305
Golder Associates Inc. (Golder) (2009) Literature review of treatment technologies to remove selenium from mining influenced water. Prepared for Teck Coal Limited, Calgary, AB. 0842–0034
Goldhaber SB (2003) Trace element risk assessment: essentiality vs. toxicity. Regul Toxicol Pharmacol 38(2):232–242
Gray NF (1996) The use of an objective index for the visual assessment of the contamination of surface water and groundwater by acid mine drainage. Water Environ J 10(5):332–340
Greald F, Combs J, Gray WP (1998) Chemopreventive agents: selenium. Pharmacol Ther 79(3):179–192
Hall RA, Jones WE, Subramanian KN (1980) Process for removal of selenium and tellurium from copper bearing liquors. Canadian Patent 1081470
Hamilton SJ (2004) Review of selenium toxicity in the aquatic food chain. Sci Total Environ 326(1–3):1–31
Harris B, White C (2011a) A non-cyanide route for processing of refractory gold ores and concentrates. In: Alta conference 2011, pp 18
Harris B, White C (2011b) Process for the recovery of gold from an ore in chloride medium with a nitrogen species. WO 2001/100821 A1
Hassan RM (1991) Kinetics and mechanism of selenium (IV) oxidation of ascorbic acid in aqueous perchlorate solutions. Croat Chem Acta 64(2):229–236
Hemalatha T, Krithiga G, Kumar BS, Sastry TP (2014) Preparation and characterization of hydroxyapatite-coated selenium nanoparticles and their interaction with osteosarcoma (SaOS-2) cells. Acta Metall Sin (Engl Lett) 27(6):1152–1158
Hollander ML, Yurii E (1956) Recovery of selenate values contained in sulfuric acid solutions. US Patent 2834652
Hyvarinen O, Hamalainen M, Lamberg P, Lippo J (2004) Recovering gold from copper concentrate via the HydroCopper process. JOM 56(8):57–59
Jain R, Matassa S, Singh S, van Hullebusch ED, Esposito G, Lens PNL (2016) Reduction of selenite to elemental selenium nanoparticles by activated sludge. Environ Sci Pollut Res 23(2):1193–1202
Johnson DB, Hallberg KB (2005) Acid mine drainage remediation options: a review. Sci Total Environ 338:3–14
Kapoor A, Tanjore S, Viraraghavan T (1995) Removal of selenium from water and wastewater. Int J Environ Stud 49:137–147
Kharaka YK, Ambats G, Presser TS (1996) Removal of selenium from contaminated agricultural drainage water by nanofiltration membranes. Appl Geochem 11:797–802
Khamkhash A, Srivastava V, Ghosh T, Akdogan G, Ganguli R, Aggarwal S (2017) Mining-related selenium contamination in Alaska, and the state of current knowledge. Minerals 7:46–59
Kora AJ, Rastogi L (2016) Biomimetic synthesis of selenium nanoparticles by pseudomonas aeruginosa ATCC 27853: an approach for conversion of selenite. J Environ Manag 181:231–236
Koyama K, Kobayashi M, Tsunashima A (2000) Removal of selenium in effluents of metal refineries by chemical reduction using solid iron. In: Young C (ed) minor elements 2000: processing and environmental aspects of as, Sb, se, Te, and bi. Society for Mining, metallurgy, and exploration, Inc., Littleton, pp 363–370
Laitnen R, Steudel R (1980) Vibrational spectroscopic investigations of SnSe8-n molecules. J Mol Struct 68:19–32
Lemly AD (2004) Aquatic selenium pollution is a global environmental safety issue. Ecotoxicol Environ Saf 59:44–56
Levine VE (1934) Precipitation and color reaction for ascorbic acid: specificity of acidified sodium selenite solution. Proc Soc Exp Biol 35:231–235
Liddell KS, Adams MD (2012) Kell hydrometallurgical process for extraction of platinum group metals and base metals from flotation concentrates. J S Afr Inst Min Metall Trans 112:31–36
Lyubenova L, Sabodash X, Schroder P, Michalke B (2015) Selenium species in the roots and shoots of chickpea plants treated with different concentrations of sodium selenite. Environ Sci Pollut Res 22(21):16978–16986
Marchant WN, Dannenberg RO, Brooks PT (1978) Selenium removal from acidic waste water using zinc reduction and lime neutralization. US Bureau of Mines, Salt Lake City
Matos-Reyes MN, Cervera ML, Campos RC, de la Guardia M (2010) Total content of as, Sb, Se, Te and Bi in Spanish vegetables, cereals and pulses and estimation of the contribution of these foods to the Mediterranean daily intake of trace elements. Food Chem 122(1):188–194
Mayhew K, Coy MC, Mean R, Woeller J (2013) Teck’s CESL copper process: a commercial ready concentrate leach alternative. In: Presented at Copper 2013. http://www.cesl.com
McCloskey J, Twidwell L, Park B, Fallon M (2008) Removal of selenium oxyanions from industrial scrubber waters utilizing elemental iron. In: Young CA, Taylor PR, Anderson CG (Eds.), Hydrometallurgy 2008: Proceedings of the Sixth International Symposium. Society for Mining, Metallurgy, and Exploration (SME), Colorado, USA, pp. 140–148
Misra GJ, Tandon JP (1967) Gravimetric determination of selenium using copper chloride as reducing agent. Indian J Chem 5(11):560–562
Monteith G, Houlachi G, Pineau M, Laliberté M (2000) Development, testing and full-scale operation of a new treatment method for Selenium removal from acidic effluents. In: Dutrizac J, Gonzales JA, Henke DM, James SE, Siegmund AHJ (eds) Lead-zinc 2000. The Minerals, Metals and Materials Society, Pittsburg, pp 879–880
Moyes J (1999) The Intec copper process demonstration plant operating experience and results from the 1999 campaign. In: copper concentrate treatment short course, unpublished presentation given at copper 99, Phoenix, Arizona
MSE (2000) Issues identification and technology prioritization report: Selenium. EPA Mine Waste Technology Program (MWTP): Volume VII, MWTP-106. 118p
Murphy AP (1988) Removal of selenate from water by chemical reMurphy, A.P. Method of selectively removing selenium ions from duction. Ind Eng Chem 27:187–191
Muscatello JR, Belknao AM, Janz DM (2008) Accumulation of selenium in aquatic systems downstream of a uranium mining operation in Northern Saskatchewan, Canada. Environ Pollut 156:387–393
Natasha SM, Niazi NK, KhalidS MB, Bibi I, Rashid MI (2018) A critical review of selenium biogeochemical behaviour in soil-plant system with an inference to human health. Environ Pollut 234:915–934
Nordstrom DK, Alpers CN, Ptacek CJ, Blowes DW (2000) Negative pH and extremely acidic mine waters from iron mountain, California. Environ Sci Technol 34:254–258
Oremland RS, Herbel MJ, Blum JD, Langley S, Beveridge TJ, Ajayan PM, Sutton T, Ellis AV, Curran S (2004) Structural and spectral features of selenium nanospheres produced by se-respiring bacteria. Appl Environ Microbiol 70(1):52–60
Pefait P, Simon L, Genin JR (2000) Reduction of SeO4 2− anions and anoxic formation of iron(II)-iron(III) hydroxy-selenate green rust. Environ Sci Technol 34:819–825
Peng A, Xu LQ (1987) The effects of humic acid on the chemical and biological properties of selenium in the environment. Sci Total Environ 64:89–98
Pettine M (2013) The reaction of selenium(IV) with ascorbic acid: its relevance in aqueous and soil systems. Chemosphere 90:245–250
Qin HB, Zhu JM, Lin ZQ, Xu WP, Tan DC, Zheng LR, Takahashi Y (2017a) Selenite speciation in seleniferious agricultural soils under different cropping systems using sequential extraction and X-ray absorption spectroscopy. Environ Pollut 225:361–369
Qin HJ, Li JX, Yang HY, Pan BC, Zhang WM, Guan XH (2017b) Coupled effect of ferrous ion and oxygen on the electron selectivity of zerovalent iron for selenate sequestration. Environ Sci Technol 51:5090–5097
Qiu JH, Wang QQ, Ma YN, Yang LM, Huang BL (2006) On-line pre-reduction of Se(VI) by thiourea for selenium speciation by hydride generation. Spectrochim Acta 61B:803–809
Rayman MP (2000) The importance of selenium to human health. Lancet 356:233–241
Sandy T, DiSante C (2010) Review of available technologies for the removal of selenium from water. Prepared for the north American metals council-selenium working group, Washington D.C., CH2M HILL June, 1-233
Santos S, Ungureanu G, Boaventura R, Botelho C (2015) Selenium contaminated waters: an overview of analytical methods, treatment options and recent advances in sorption methods. Sci Total Environ 521-522:246–260
Severs K (1999) Technological advances in treating copper concentrates: the Intec copper process. In: paper presented at the 128th SME meeting, Denver, Colorado, march, 1999
Shaker AM (1996) Kinetics of the reduction of Se(IV) to Se-Sol. J Colloid Interface Sci 180:225–231
Staicu LC, van Hullebusch ED, Oturan M, Ackerson CJ, Lens PNL (2015) Removal of colloidal biogenic selenium from wastewater. Chemosphere 125:130–138
Steinberg NA, Oremland RS (1990) Dissimilatory selenate reduction potentials in a diversity of sediment types. Appl Environ Microbiol 56:3550–3557
Taylor JB, Reynolds LP, Redmer DA, Caton JS (2009) Maternal and fetal tissue selenium loads in nulliparous ewes fed supranutritional and excessive selenium during mid- to late pregnancy. J Anim Sci 87:1828–1834
Tomicek O (1927) Determination of selenium and of tellurium by means of titanium trichloride. Bull Soc Chim 41:1389–1399
Tuzen M, Sari A (2010) Biosorption of selenium from aqueous solution by green algae (Cladophora hutchinsiae) biomass: equilibrium, thermodynamic and kinetic studies. Chem Eng J 158:200–206
Twidwell L, McCloskey J, Miranda P, Gale M (2000) Technologies and potential technologies for removing selenium from process and mine wastewater. In young, C.A. (Eds.), minor elements (2000): processing and environmental aspects of as, Sb, se, Te, and bi: proceedings and environmental aspects of as, Sb, se, Te and bi. Symposium. Society for Mining, metallurgy, and exploration (SME), Salt Lake City, USA, pp. 53–66
Uggerud H, Lund W (1995) Use of thiourea in the determination of arsenic(III), antimony, bismuth, selenium, and tellurium by hydride generation ICP-AES. J Anal At Spectrom 10:405–407
Ullal H, Liu G, Yousaf B, Ali MU, Abbas Q, Munir MAM, Mian MM (2018) Development of selenium exposure and health risk in daily foodstuffs: a systematic review and meta-analysis. Ecotoxicol Environ Saf 149:291–306
USEPA (2002) Development document for final effluent limitations guidelines and standards for the iron and steel manufacturing point source category. EPA 821-R-02-004. United States Environmental Protection Agency, Washington, DC
USEPA (2009) National primary drinking water regulations, list of contaminants and their (MCLs). EPA 816-F-09-0004. United States Environmental Protection Agency, Washington, DC
Wang D, Dinh QT, Thu TTA, Zhou F, Yang W, Wang M, Song W, Liang D (2018) Effect of selenium-enriched organic material amendment on selenium fraction transformation and biovailability in soil. Chemosphere 199:417–426
Ward AT (1968) Raman spectroscopy of sulfur, sulfur-selenium, and sulfur-arsenic mixtures. J Phys Chem 72(12):4133–4139
Wasewar KL, Prasad B, Gulipalli S (2009) Adsorption of selenium using bagasse fly ash. Clean (Weinh) 37:534–543
Welna M, Szymczycha-Madeja A, Pohl P (2014) Optimization of sample preparation of carrot fruit juice for determination of antimony, arsenic, and selenium by hydride generation-inductively coupled plasma optical emission spectrometry. Anal Lett 47:2104–2119
Welna M, Szymczycha-Madeja A, Pohl P (2017) Critical evaluation of strategies for single and simultaneous determinations of As, Bi, Sb, and Se by hydride generation inductively coupled plasma optical emission spectrometry. Talanta 167:217–226
WHO (2011) Guidelines for drinking water quality. 4th ed. Geneva. https://www.who.int/water_sanitation_health/publications/2011/dwq_guidelines/en/
Winand R (1991) Chloride hyrometallurgy. Hydrometallurgy 27:285–316
Wu L (2004) Review of 15 years of research on ecotoxicology and remediation of land contaminated by agricultural drainage sediment rich in selenium. Ecotoxicol Environ Saf 57:257–269
Yadak SK, Singh I, Singh D, Han SD (2005) Selenium status in soils of northern districts of India. J Environ Manag 75(2):129–132
Yoon IH, Bang S, Kim KW, Kim MG, Park SY, Choi WK (2016) Selenate removal by zero-valent iron in oxic conditions: the role of Fe(II) and selenate removal mechanism. Environ Sci Pollut Res 23(2):1081–1090
Zhang N, Fu N, Fang Z, Feng Y, Ke L (2011) Simultaneous multi-channel hydride generation atomic fluorescence spectrometry determination of arsenic, bismuth, tellurium and selenium in tea leaves. Food Chem 124:1185–1188
Acknowledgments
We like to thank Yi-hang Duan at the Institute of Applied Ecology for the use of Raman and ATR-IR instruments. We also like to thank Chunxiang Gao at the SYUCT for the collection of the XRD data and Guangzhou Weiping Technology Service Co., Ltd. for TEM analysis. Finally, the authors would like to thank Baiyi Wang and Bing Han at SYUCT for additional experimental work used in the revision of this manuscript. This study was supported by the National Natural Science Foundation of China No. 41703129 and the National Key R&D Program of China No. 2017 YFD 0800301.
Author information
Authors and Affiliations
Corresponding authors
Additional information
Responsible editor: Ioannis A. Katsoyiannis
Publisher’s note
Springer Nature remains neutral with regard to jurisdictional claims in published maps and institutional affiliations.
Electronic supplementary material
Supplementary material
The supporting information contains 6 Tables and 9 Figures not included in the main body of the text but discussed in the body of the manuscript. (DOCX 2974 kb)
Rights and permissions
About this article
Cite this article
Zhang, G., Gomez, M.A., Yao, S. et al. Systematic study on the reduction efficiency of ascorbic acid and thiourea on selenate and selenite at high and trace concentrations. Environ Sci Pollut Res 26, 10159–10173 (2019). https://doi.org/10.1007/s11356-019-04383-z
Received:
Accepted:
Published:
Issue Date:
DOI: https://doi.org/10.1007/s11356-019-04383-z